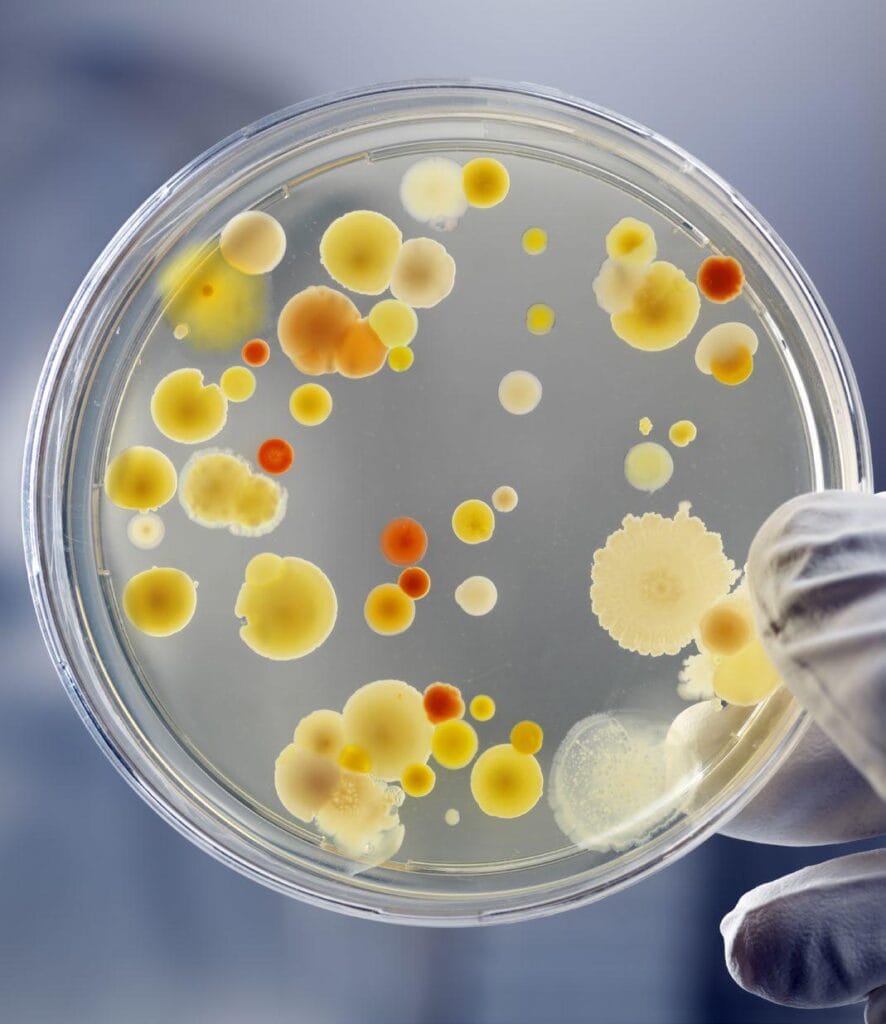
Producción de camarones

Los probióticos se utilizan cada vez más en la acuicultura para proteger a los organismos cultivados de los patógenos, mejorar la calidad del agua y la eficacia de la alimentación, especialmente en el caso de los camarones, la especie acuícola más cultivada en todo el mundo. En este artículo se resumen los retos actuales que afectan la acuicultura del camarón y cómo contribuyen los probióticos para mejorar la producción.
La acuicultura representa una solución potencial a los problemas de la inseguridad alimentaria y la malnutrición en el mundo. Varias especies acuáticas, entre ellas peces, crustáceos y plantas acuáticas, se cultivan mediante la acuicultura, la cual requiere la aplicación de métodos de gestión de la calidad como inventario diario, alimentación y protección contra depredadores.
El creciente mercado y la intensificación de la producción acuícola han contribuido a la aparición de enfermedades y al deterioro de las condiciones medioambientales.
Estos problemas suponen importantes amenazas para los grandes sistemas de producción en los que los camarones de cultivo están sometidos a condiciones deficientes. En condiciones de estrés, Litopenaeus vannamei es susceptible a diversos patógenos, como el virus de la mancha blanca, el virus de la cabeza amarilla y bacterias patógenas como Vibrio spp que causan vibriosis.
El método más común para prevenir enfermedades es la aplicación de antimicrobianos y antibióticos. Sin embargo, este ha promovido la proliferación de bacterias resistentes a los antibióticos, originando riesgos medioambientales y deposición de residuos de antibióticos en los tejidos.
Además de la prevención de enfermedades, la nutrición adecuada es un factor crítico que afecta a la acuicultura. El éxito de la producción acuícola depende de una dieta nutricionalmente equilibrada y de unos costos de producción bajos.
La aplicación de probióticos en la industria puede servir para controlar los patógenos y mejorar la eficiencia de conversión de los alimentos.
Infección por Vibrio en camarones
En la Tabla 1 se presentan las enfermedades más comunes que amenazan la producción acuícola de camarones. Con la expansión de la cría de camarones, desde las prácticas tradicionales a pequeña escala a la acuicultura intensiva moderna, también ha aumentado la complejidad de las enfermedades del camarón en la India.

Las interacciones entre patógenos, hospedadores y entorno de los estanques, son factores clave en el desarrollo de las enfermedades. La vibriosis es la principal enfermedad bacteriana que afecta a la acuicultura del camarón.
Altos niveles de Vibrio spp en los estanques de engorde se asocian con necrosis interna y externa, reducción de las tasas de alimentación, alteración del intestino, decoloración roja de los camarones (particularmente de la cola), alta mortalidad y reducción de la inmunidad, lo que aumenta la susceptibilidad de los camarones a infecciones secundarias.
Los intentos de regular y evitar estos patógenos han contribuido al uso generalizado de antimicrobianos y productos veterinarios.
Probióticos acuícolas
En acuicultura, los suplementos microbianos inhiben microorganismos patógenos, aumentando el valor del alimento, contribuyendo enzimáticamente a la digestión, segregando factores de crecimiento de respuesta inmunitaria y mejorando la calidad del agua.
Diversos investigadores han estudiado el uso de probióticos innovadores en la acuicultura. La Tabla 2 destaca los probióticos usados actualmente en el cultivo de camarones y la Figura 1 ilustra diversos modos de acción de los probióticos.


Los efectos antagónicos de los probióticos se han demostrado en varios estudios. La evaluación del perfil de crecimiento de los probióticos y la determinación de la fase de producción de metabolitos anti-Vibrio es esencial, ya que la mayoría de los metabolitos se producen durante la fase estacionaria de crecimiento, que no se produce in vivo debido al lavado frecuente del intestino.
Los probióticos también han desempeñado un papel importante en el desarrollo de enzimas y otros compuestos beneficiosos que favorecen la digestión y mejoran la calidad del agua, además de su actividad contra las enfermedades patógenas (Vine et al., 2006).
“Diversos estudios han informado que la suplementación, con probióticos, mejora profundamente la inmunidad inespecífica y la supervivencia de los camarones en acuicultura.”
Las asociaciones microbianas desempeñan un papel importante en el control del equilibrio entre microorganismos beneficiosos y patógenos opuestos. La introducción de un probiótico que compita, por los sitios de adhesión, es un método creíble para evitar que las bacterias no deseadas colonicen el intestino u otras superficies tisulares.
La Tabla 3 muestra algunas fuentes de bacterias probióticas empleadas en la acuicultura del camarón. Otro factor importante es la producción de compuestos beneficiosos y su influencia en la calidad del agua. Se han estudiado los efectos de los probióticos en la calidad del agua del medio receptor, ya que la acuicultura genera compuestos nitrogenados nocivos, como el amoníaco tóxico, que deben ser tratados.

Diversos estudios sugieren que los microorganismos minimizan el nitrito y el amoníaco y promueven la descomposición de la materia orgánica en los estanques de acuicultura. La Figura 2 ilustra el papel de diferentes probióticos en el mejoramiento de la calidad del agua.

Selección de probióticos
El desarrollo de probióticos implica una amplia evaluación in vitro e in vivo, que garantice que los microorganismos aislados de diferentes fuentes apoyarán al huésped mediante la transmisión de resistencia a las enfermedades y mejorarán el entorno acuático circundante.
Para preseleccionar las cepas potenciales se realizan diversos experimentos in vitro, como evaluación de la inhibición de patógenos, producción de sustancias antimicrobianas, producción de enzimas digestivas, capacidad de adherirse al epitelio intestinal y tasa de crecimiento.
Actividad antimicrobiana in vitro
La selección de los microorganismos adecuados es uno de los factores más esenciales en el diseño de un probiótico. Metódicamente, se realiza un gran número de pruebas in vitro que examinan la actividad antimicrobiana para eliminar los candidatos inadecuados, reduciendo el número de experimentos in vivo necesarios para autentificar la eficacia del probiótico.
La mayoría de los experimentos de filtrado incluyen el antagonismo in vitro, en el que los agentes patógenos se someten específicamente a cocultivos en medios sólidos o líquidos o a pruebas difusivas.
Evaluación in vitro de la adhesión al moco
Algunas bacterias solo secretan metabolitos en la fase estacionaria de crecimiento, lo que no ocurre in vivo debido al lavado intestinal continuo. La supervivencia de las bacterias dentro del tracto gastrointestinal del huésped se preserva mediante la adhesión al moco y, por tanto, se trata como un estado de colonización.
La incapacidad de adherirse a la mucosa de la pared intestinal implica que estas bacterias no pueden contrarrestar el lavado durante la evacuación intestinal. Así, los probióticos potenciales deben examinarse in vitro para determinar sus propiedades de adhesión a la mucosa antes de realizar ensayos exhaustivos in vivo.
Pruebas de patogenicidad in vivo
Es obligatorio asegurarse de que el microorganismo probiótico candidato no sea nocivo y no patógeno para el hospedador. Algunos Bacillus spp producen una toxina hemolisina que puede ser perjudicial para el hospedador. La capacidad hemolítica de las bacterias puede comprobarse en agar sangre.
La capacidad protectora del probiótico también puede probarse en circunstancias normales y exigentes amenazando al hospedador con un probiótico reconocido. Esto puede confirmarse mediante pruebas de desafío a especies huésped a pequeña escala utilizando suspensiones bacterianas, estanques temporales, desafíos por infusión o incorporación inmediata al agua del tanque.
“En la validación in vivo, el hospedador debe exponerse al probiótico candidato para la evaluación in vivo del desarrollo, la supervivencia y los parámetros inmunológicos y físicoquímicos durante un periodo de prueba determinado.”
En cuanto a la evaluación de la seguridad de los probióticos, dado que desempeñan un papel crucial en la estimulación de la inmunidad de los organismos cultivados, es importante garantizar que no dañen a sus respectivos huéspedes. El potencial de los cultivos bacterianos, vivos o de sus metabolitos bioactivos para causar daños al organismo objetivo, debe examinarse para
descartar cualquier efecto adverso antes de su aplicación comercial.
Las tres preocupaciones principales relativas a la seguridad de los probióticos son la aparición de enfermedades, los efectos tóxicos en el tracto gastrointestinal del huésped y la transferencia de genes resistentes a los antibióticos.
Conclusión
Los probióticos son promotores del crecimiento y agentes de control de patógenos prometedores y seguros, y su aplicación mejorará la producción de camarones y el entorno del acuario.

La versión informativa del artículo original está patrocinada por: GRUPO GAM

Esta es una versión resumida desarrollada por el equipo editorial de Panorama Acuícola Magazine del artículo “SHRIMP PRODUCTION, THE MOST IMPORTANT DISEASES THAT THREATEN IT, AND THE ROLE OF PROBIOTICS IN CONFRONTING THESE DISEASES: A REVIEW” escrito por MOHAMED T. EL-SAADONY- Zagazig University; AYMAN A. SWELUM – King Saud University and Zagazig University; MAHMOUD M. ABO GHANIMA- Damanhour University; MUSTAFA SHUKRY – Kafrelsheikh University; AMIRA A. OMAR -Kafrelsheikh University; AYMAN E. TAHA – Alexandria University; HEBA M. SALEM Cairo University; AMIRA M. EL-TAHAN – Arid Lands Cultivation Research Institute; KHALED A. EL-TARABILY – United Arab Emirates University and Murdoch University; MOHAMED E. ABD EL-HACK – Zagazig University.
La versión original, incluyendo tablas y figuras, fue publicada en ENERO de 2022 en RESEARCH IN VETERINARY SCIENCE.
Se puede acceder a la versión completa a través de https://doi.org/10.1016/j.rvsc.2022.01.009.



